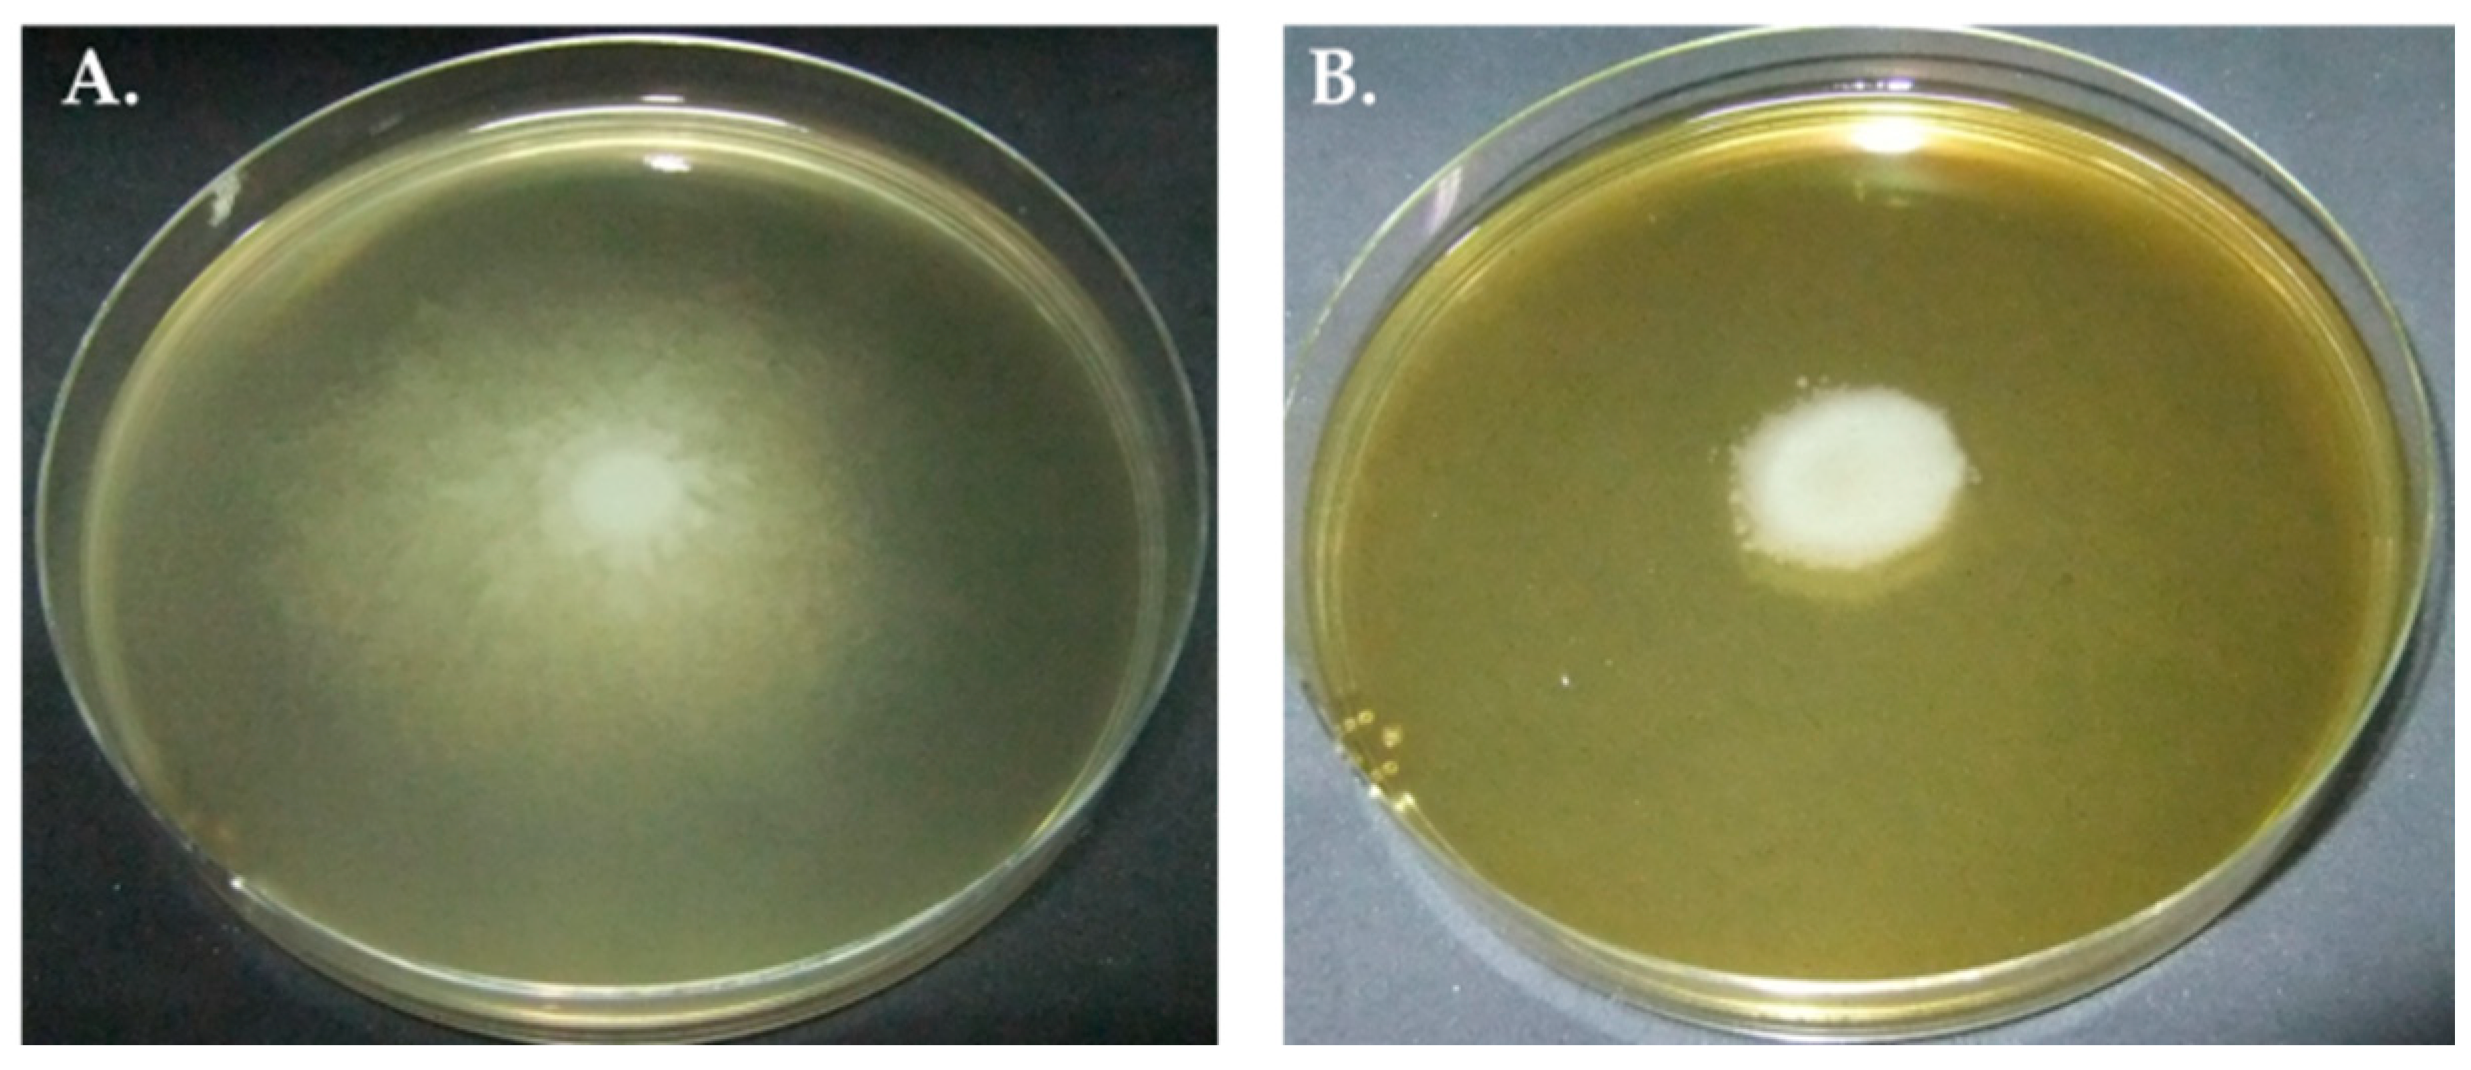
Molecules 27 01092 g001

Anti-Proteus Activity, Anti-Struvite Crystal, and Phytochemical Analysis of Sida acuta Burm. F. Ethanolic Leaf Extract
Abstract
:1. Introduction
2. Results
2.1. Minimum Inhibitory Concentration (MIC) of SAEE on P. mirabilis
2.2. Inhibitory Effect of SAEE on Swarming Migration of P. mirabilis
2.3. Inhibitory Effect of SAEE on Urease Activity of P. mirabilis
2.4. Inhibition of Struvite Crystal Weights by SAEE
2.5. Identification and Confirmation of Struvite Crystal
2.6. Determination of Phytochemical Constituents of SAEE
3. Discussion
4. Materials and Methods
4.1. Ethics
4.2. Sample Collection and Selection Criteria
4.3. Determination of the Antibacterial Activity of SAEE
4.4. Inhibitory Effect of SAEE on Swarming Motility of P. mirabilis
4.5. Inhibitory Effect of SAEE on Urease Activity of P. mirabilis
4.6. Inhibition of Struvite Crystal Formation by SAEE
4.7. Identification of Struvite Crystals
4.8. Extraction of SA Leaves
4.9. Analysis of SAEE Constituents Using High-Performance Liquid Chromatography (HPLC)
4.10. Statistical Analysis
5. Conclusions
Author Contributions
Funding
Institutional Review Board Statement
Informed Consent Statement
Data Availability Statement
Acknowledgments
Conflicts of Interest
Sample Availability
References
- Sriboonlue, P.; Prasongwatana, V.; Chata, K.; Tungsanga, K. Prevalence of upper urinary tract stone disease in a rural community of north-eastern Thailand. Br. J. Urol. 1992, 69, 240–244. [Google Scholar] [CrossRef]
- Sritippayawan, S.; Borvornpadungkitti, S.; Paemanee, A.; Predanon, C.; Susaengrat, W.; Chuawattana, D.; Sawasdee, N.; Nakjang, S.; Pongtepaditep, S.; Nettuwakul, C.; et al. Evidence suggesting a genetic contribution to kidney stone in northeastern Thai population. Urol. Res. 2009, 37, 141–146. [Google Scholar] [CrossRef]
- Miano, R.; Germani, S.; Vespasiani, G. Stones and urinary tract infections. Urol. Int. 2007, 79, 32–36. [Google Scholar] [CrossRef] [PubMed]
- Saelee, K.; Tavichakorntrakool, R.; Amimanan, P.; Lulitanond, A.; Boonsiri, P.; Prasongwatana, V.; Wongkham, C.; Sribenjalux, P. Induction of crystal formation in artificial urine by Proteus mirabilis isolated from kidney stone patients. J. Med. Technol. Phys. Ther. 2016, 28, 129–134. [Google Scholar]
- Tavichakorntrakool, R.; Prasongwattana, V.; Sungkeeree, S.; Saisud, P.; Sribenjalux, P.; Pimratana, C.; Bovornpadungkitti, S.; Sriboonlue, P.; Thongboonkerd, V. Extensive characterizations of bacteria isolated from catheterized urine and stone matrices in patients with nephrolithiasis. Nephrol. Dial. Transplant. 2012, 27, 4125–4130. [Google Scholar] [CrossRef] [PubMed] [Green Version]
- Armbruster, C.E.; Mobley, H.L.; Pearson, M.M. Pathogenesis of Proteus mirabilis infection. EcoSal Plus 2018, 8. [Google Scholar] [CrossRef] [PubMed] [Green Version]
- Yuan, F.; Huang, Z.; Yang, T.; Wang, G.; Li, P.; Yang, B.; Li, J. Pathogenesis of Proteus mirabilis in catheter-associated urinary tract infections. Urol. Int. 2021, 105, 354–361. [Google Scholar] [CrossRef]
- Wollin, D.A.; Joyce, A.D.; Gupta, M.; Wong, M.Y.C.; Laguna, P.; Gravas, S.; Gutierrez, J.; Cormio, L.; Wang, K.; Preminger, G.M. Antibiotic use and the prevention and management of infectious complications in stone disease. World J. Urol. 2017, 35, 1369–1379. [Google Scholar] [CrossRef] [PubMed]
- Abat, J.K.; Kumar, S.; Mohanty, A. Ethnomedicinal, phytochemical and ethnopharmacological aspects of four medicinal plants of Malvaceae used in Indian traditional medicines: A review. Medicines 2017, 4, 75. [Google Scholar] [CrossRef] [Green Version]
- Benjumea, D.M.; Gómez-Betancur, I.C.; Vásquez, J.; Alzate, F.; García-Silva, A.; Fontenla, J.A. Neuropharmacological effects of the ethanolic extract of Sida acuta. Rev. Bras. Farmacogn. 2016, 26, 209–215. [Google Scholar] [CrossRef] [Green Version]
- Chumpol, W.; Tavichakorntrakool, R.; Lulitanond, A.; Daduang, J.; Saisud, P.; Sribenjalux, P.; Prasongwatana, V.; Boonsiri, P. The antibacterial activity of the aqueous extract of Sida acuta Burm. F. Southeast Asian J. Trop. Med. Public Health 2018, 49, 285–291. [Google Scholar]
- Hussein, E.I.; Al-Batayneh, K.; Masadeh, M.M.; Dahadhah, F.W.; Al Zoubi, M.S.; Aljabali, A.A.; Alzoubi, K.H. Assessment of pathogenic potential, virulent genes profile, and antibiotic susceptibility of Proteus mirabilis from urinary tract infection. Int. J. Microbiol. 2020, 2020, 1231807. [Google Scholar] [CrossRef] [Green Version]
- Enechi, O.C.; Amah, C.C.; Okagu, I.U.; Ononiwu, P.C.; Nweke, A.C.; Ugwuanyi, T.C.; Ajibo, E.A.; Nweze, A.C.; Chukwurah, B.C. Sida acuta Burm. F. leaves ethanol extract ameliorates haematological and biochemical alterations induced by Plasmodium berghei ANKA-65 in mice. Clin. Phytoscience. 2021, 7, 78. [Google Scholar] [CrossRef]
- Ekpo, M.A.; Etim, P.C. Antimicrobial activity of ethanolic and aqueous extracts of Sida acuta on microorganisms from skin infections. J. Med. Plants Res. 2009, 3, 621–624. [Google Scholar]
- Bouarab-Chibane, L.; Forquet, V.; Lantéri, P.; Clément, Y.; Léonard-Akkari, L.; Oulahal, N.; Degraeve, P.; Bordes, C. Antibacterial properties of polyphenols: Characterization and QSAR (Quantitative Structure-Activity Relationship) models. Front. Microbiol. 2019, 10, 829. [Google Scholar] [CrossRef] [PubMed]
- Xie, Y.; Yang, W.; Tang, F.; Chen, X.; Ren, L. Antibacterial activities of flavonoids: Structure-activity relationship and mechanism. Curr. Med. Chem. 2015, 22, 132–149. [Google Scholar] [CrossRef]
- Fu, L.; Lu, W.; Zhou, X. Phenolic compounds and in vitro antibacterial and antioxidant activities of three tropic fruits: Persimmon, guava, and sweetsop. BioMed. Res. Int. 2016, 2016, 4287461. [Google Scholar] [CrossRef] [PubMed] [Green Version]
- Sirk, T.W.; Brown, E.F.; Sum, A.K.; Friedman, M. Molecular dynamics study on the biophysical interactions of seven green tea catechins with lipid bilayers of cell membranes. J. Agric. Food Chem. 2008, 56, 7750–7758. [Google Scholar] [CrossRef]
- Kabir, F.; Katayama, S.; Tanji, N.; Nakamura, S. Antimicrobial effects of chlorogenic acid and related compounds. J. Korean Soc. Appl. Biol. Chem. 2014, 57, 359–365. [Google Scholar] [CrossRef]
- Borges, A.; Ferreira, C.; Saavedra, M.J.; Simões, M. Antibacterial activity and mode of action of ferulic and gallic acids against pathogenic bacteria. Microb. Drug Resist. 2013, 19, 256–265. [Google Scholar] [CrossRef]
- Pimentel, R.B.; da Costa, C.A.; Albuquerque, P.M.; Junior, S.D. Antimicrobial activity and rutin identification of honey produced by the stingless bee Melipona compressipes manaosensis and commercial honey. BMC Complement Altern. Med. 2013, 13, 151. [Google Scholar] [CrossRef] [Green Version]
- Ragunathan, A.; Ravi, L. Potential antibacterial drug targets for quercetin and rutin: An in silico study using AutoDock. Der Pharm. Lett. 2015, 7, 68–72. [Google Scholar]
- Jeyaleela, G.D.; Vimala, J.R.; Senthil, R.; Anandagopu, P.; Manjula, K. Isolation, characterization, molecular docking and in vitro studies of inhibitory effect on the growth of struvite crystal derived from Melia dubia leaf extract. Asian J. Chem. 2019, 31, 2628–2634. [Google Scholar] [CrossRef]
- Clinical Laboratory Standards Institute (CLSI). Performance Standards for Antimicrobial Susceptibility Testing, 30th ed.; CLSI: Wayne, PA, USA, 2020. [Google Scholar]
- Liaw, S.-J.; Lai, H.-C.; Ho, S.-W.; Luh, K.-T.; Wang, W.-B. Inhibition of virulence factor expression and swarming differentiation in Proteus mirabilis by p-nitrophenylglycerol. J. Med. Microbiol. 2000, 49, 725–731. [Google Scholar] [CrossRef] [PubMed] [Green Version]
- Chauhan, C.K.; Joshi, M.J. Growth inhibition of struvite crystals in the presence of juice of Citrus medica Linn. Urol. Res. 2008, 36, 265–273. [Google Scholar] [CrossRef] [PubMed]
- Kapcum, C.; Uriyapongson, J. Effects of storage conditions on phytochemical and stability of purple corn cob extract powder. Food Sci. Technol. 2018, 38, 301–305. [Google Scholar] [CrossRef] [Green Version]

| P. mirabilis Strains | Distance of Swarming Motility in Conditions (cm), Median (IQR1, IQR3) | Inhibitory Effect (%) | |
|---|---|---|---|
| Without SAEE | With 1/2MIC of SAEE | ||
| PMKS1 | 8.45 (8.40–8.50) | 6.18 (5.84–7.51) | 26.86 * |
| PMKS2 | 8.45 (8.35–8.55) | 6.70 (4.79–6.82) | 20.71 * |
| PMKS3 | 8.52 (8.47–8.58) | 2.42 (2.01–3.10) | 71.60 * |
| P. mirabilis Strains | Urease Activity in Conditions (unit/L), Median (IQR1, IQR3) | Inhibitory Effect (%) | |
|---|---|---|---|
| Without SAEE | With 1/2MIC of SAEE | ||
| PMKS1 | 9.37 (8.86–9.49) | 6.02 (5.22–7.29) | 35.75 * |
| PMKS2 | 13.12 (11.63–13.43) | 7.94 (7.22–8.76) | 39.48 * |
| PMKS3 | 8.24 (6.25–8.69) | 6.98 (5.98–7.71) | 15.29 |
| Concentration of SAEE (mg/mL) | Weights of Struvite Crystals (g), Median (IQR1, IQR3) | Significance |
|---|---|---|
| 0 | 1.0470 (1.0437, 1.0668) | |
| 1 | 1.0392 (1.0367, 1.0457) | * |
| 2 | 1.0340 (1.0203, 1.0404) | * |
| 4 | 1.0363 (1.0224, 1.0390) | * |
| 8 | 1.0292 (1.0262, 1.0348) | * |
| 16 | 1.0255 (1.0232, 1.0344) | *, ** |
| 32 | 1.0137 (1.0090, 1.0155) | *, **, #, & |
Publisher’s Note: MDPI stays neutral with regard to jurisdictional claims in published maps and institutional affiliations. |
© 2022 by the authors. Licensee MDPI, Basel, Switzerland. This article is an open access article distributed under the terms and conditions of the Creative Commons Attribution (CC BY) license (https://creativecommons.org/licenses/by/4.0/).
Share and Cite
Smanthong, N.; Tavichakorntrakool, R.; Tippayawat, P.; Lulitanond, A.; Pinlaor, P.; Daduang, J.; Sae-ung, N.; Chaveerach, A.; Phetcharaburanin, J.; Boonsiri, P. Anti-Proteus Activity, Anti-Struvite Crystal, and Phytochemical Analysis of Sida acuta Burm. F. Ethanolic Leaf Extract. Molecules 2022, 27, 1092. https://doi.org/10.3390/molecules27031092
Smanthong N, Tavichakorntrakool R, Tippayawat P, Lulitanond A, Pinlaor P, Daduang J, Sae-ung N, Chaveerach A, Phetcharaburanin J, Boonsiri P. Anti-Proteus Activity, Anti-Struvite Crystal, and Phytochemical Analysis of Sida acuta Burm. F. Ethanolic Leaf Extract. Molecules. 2022; 27(3):1092. https://doi.org/10.3390/molecules27031092
Chicago/Turabian StyleSmanthong, Nitis, Ratree Tavichakorntrakool, Patcharaporn Tippayawat, Aroonlug Lulitanond, Porntip Pinlaor, Jureerut Daduang, Nattaya Sae-ung, Arunrat Chaveerach, Jutarop Phetcharaburanin, and Patcharee Boonsiri. 2022. "Anti-Proteus Activity, Anti-Struvite Crystal, and Phytochemical Analysis of Sida acuta Burm. F. Ethanolic Leaf Extract" Molecules 27, no. 3: 1092. https://doi.org/10.3390/molecules27031092
APA StyleSmanthong, N., Tavichakorntrakool, R., Tippayawat, P., Lulitanond, A., Pinlaor, P., Daduang, J., Sae-ung, N., Chaveerach, A., Phetcharaburanin, J., & Boonsiri, P. (2022). Anti-Proteus Activity, Anti-Struvite Crystal, and Phytochemical Analysis of Sida acuta Burm. F. Ethanolic Leaf Extract. Molecules, 27(3), 1092. https://doi.org/10.3390/molecules27031092

